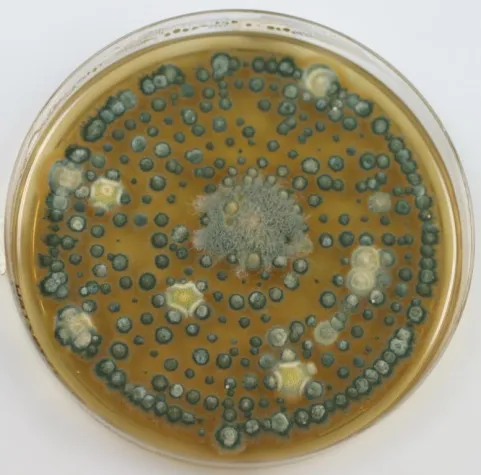
Bild: Schimmelpilze - wie viele Arten sind relevant in Innenräumen

(openPR) Schimmelpilze gehören zu unserer natürlichen Umwelt. Sie sind im Freien als auch in Innenräumen praktisch immer vorhanden.
Wenn es um Schimmelpilzbefall in Innenräumen geht, wird auf Fachveranstaltungen, in Foren oder in Presseartikeln vielfach darauf hingewiesen, dass es mehr als 100.000 verschiedene Schimmelpilzarten gibt. Dies geschieht mit dem oft angstmachenden Hinweis der Gefährdung durch Schimmelpilzallergene und Gifte (Mykotoxine).
Dadurch wird der Eindruck erweckt, dass in Innenräumen eine extreme Gefährdung durch Tausende von Schimmelpilzarten besteht. Bei solchen Aussagen wird nicht berücksichtigt, dass bei geschätzt mehr als 90% aller Sanierungsfälle nur ungefähr 30 Schimmelpilzarten im Innenraum relevant sind.
JatiProducts möchte an dieser Stelle zur Aufklärung/Information beitragen und auf die Seite http://jatiproducts.de/schimmelpilze.html hinweisen, auf der die baurelevanten Schimmelpilzarten aufgeführt sind.
Presseinformation
Schimmelpilze - wie viele Arten sind relevant in Innenräumen

Diese Pressemeldung wurde auf openPR veröffentlicht.
Verantwortlich für diese Pressemeldung:JatiProducts
Kreuzberg 4
59969 Hallenberg
Tel: 02984-93493-0
Fax: 02984-93493-29
Email:
www.jatiproducts.de
Kreuzberg 4
59969 Hallenberg
Tel: 02984-93493-0
Fax: 02984-93493-29
Email:
www.jatiproducts.de
Über das Unternehmen
JatiProducts bietet eine umfassende Produktpalette zur Bekämpfung von Schimmelpilzbefall in Innenräumen auf Basis von Wasserstoffperoxid mit stabilisierenden Fruchtsäuren an. Mit Jati Schimmelpilz-Entferner, Jati Oberflächen-Entkeimer, Jati Protect, Jati Sporen-Vernichter, Jati EstrichDämm-Desinfektion und Jati 2K-DesinfektionsSchaum findet man bei JatiProducts hochwirksame Produkte gegen Schimmelpilze, Sporen und Bakterien auf Oberflächen, in der Raumluft, in Dämmschichten unterhalb des Estrichs sowie in Hohlräumen. JatiProducts ist nach DIN EN ISO 9001:2008 zertifiziert.
Pressebericht „Schimmelpilze - wie viele Arten sind relevant in Innenräumen“ bearbeiten oder mit dem "Super-PR-Sparpaket" stark hervorheben, zielgerichtet an Journalisten & Top50 Online-Portale verbreiten:
Disclaimer: Für den obigen Pressetext inkl. etwaiger Bilder/ Videos ist ausschließlich der im Text angegebene Kontakt verantwortlich. Der Webseitenanbieter distanziert sich ausdrücklich von den Inhalten Dritter und macht sich diese nicht zu eigen. Wenn Sie die obigen Informationen redaktionell nutzen möchten, so wenden Sie sich bitte an den obigen Pressekontakt. Bei einer Veröffentlichung bitten wir um ein Belegexemplar oder Quellenennung der URL.
Weitere Mitteilungen von JatiProducts


Mit Wasser und Schlamm kommen Schimmel und Bakterien
Die Folgen von Unwetter und Hochwasser werden von Betroffenen oft unterschätzt. Nur das Wasser abzupumpen und die Flächen grob zu reinigen reicht nicht. Keimabtötende Maßnahmen sind dann erforderlich.
------------------------------
Berlin/Hallenberg. Nach den schweren Unwettern in weiten Teilen Deutschlands ist das Wasser auf dem Rückzug. Doch die Folgen der Überschwemmungen werden die Menschen in den betroffenen Gebieten noch lange beschäftigen. Mit den Wasser- und Schlammmassen in vielen Kellern, in den Hausfluren, Wohnzimmern, Turnhallen …


Desinfizieren von kontaminierten Dachstühlen
Für den Einsatz in kontaminierten Dachstühlen wurde speziell Jati Dachstuhl-Schaum entwickelt. Der Schaum wird mit Hilfe eines Schaumgerätes flächig aufgetragen und kann auch in kleinere Hohlräume, Fugen, Risse, Auflager von Sparren und im Bereich der Klauen zwischen Sparren und Pfetten eingepresst werden. Durch das Einbringen des gut sichtbaren Schaums in schlecht erreichbare Dachstuhl-Bereiche ergeben sich sichere Desinfektionsmöglichkeiten. Schimmelpilze und Bakterien werden sicher innerhalb von 20 Minuten abgetötet. Nach kurzer Einwirkzei…
Das könnte Sie auch interessieren:

Schwarze Hingucker: Schimmel in der Wohnung nachhaltig bekämpfen
Spätestens beim Frühjahrsputz fallen Schimmelpilze an der Wand auf. Sie können Allergien auslösen. Typische Anzeichen sind Husten, Schnupfen, Kopfschmerzen und Müdigkeit. Sogar Asthma kann die Folge sein. Bei Beschwerden sollten Betroffene zu ihrem Hausarzt gehen. Wird eine Schimmelpilzallergie nachgewiesen, sollte die Wohnung untersucht und wenn nötig …


Schimmelpilze mit Jati-Schimmelpilz-Entferner selbst entfernen
… von Eigentümern oder Mietern selbst behandelt werden sollten.
Diese Empfehlung ist auf eine Reihe von maßgeblichen Gründen zurückzuführen. Zum einen können Schimmelpilze negative gesundheitliche Auswirkungen auf Menschen und Tiere haben. Hierbei ist zu berücksichtigen, dass auch abgetöteten Schimmelpilzen allergene oder toxische Wirkung zugesprochen …

Schimmel im Innenraum - wie kommt der da hin?
… zu analysieren – hier muss die Ursache ermittelt und abgestellt und dann der Schimmelbefall entfernt werden.
Die korrekte Ursachenermittlung für das Wachstum von Schimmelpilzen in Innenräumen ist entscheidend, um den Schimmelbefall wirksam und dauerhaft beseitigen zu können. Die Entscheidung, welche Untersuchungsstrategie im konkreten Fall anzuwenden …

Kein Fall für Heimwerker – Schimmelpilzbekämpfung sollte Sachverständigen überlassen werden
Bonn/Seßlach – Schimmelpilze sitzen nicht auf dem Trockenen. Sie sind ein natürlicher Teil unserer belebten Umwelt. Schimmelpilze sind nicht nur ein optisches Problem. Ernsthafte Erkrankungen der Lunge, Infektionen oder Allergien können die Folge sein. Besonders heimtückisch ist der verdeckte Schimmelpilzbefall, den man nicht unbedingt an einem modrigen …


Gefährden Schimmelpilze in Innenräumen die Gesundheit?
… Konstruktionsfehler, Havarien wie Wassereinbrüche oder Leitungsleckagen, Neubaufeuchte etc.
Die Liste der möglichen Ursachen ist lang und oft kommen mehrere Bedingungen zusammen, die den Schimmelpilzen die notwendigen Wachstumsbedingungen bieten.
In der Mehrzahl der Fälle handelt es sich um verdeckte Schäden, die zuvor z.B. nur durch ihren unangenehmen Geruch …


Mycomed - Zuverlässiger Nachweis von Schimmelpilzen - Schimmel im Haus - Was tun?
… Bei Verdacht auf Schimmelpilzbelastung der Wohnräume oder bei konkreten Schadensfällen sollte eine sachgemäße Untersuchung und gegebenenfalls schnelle Beseitigung der Schimmelpilze eingeleitet werden.
Durch Untersuchung von Schimmelpilzen in einem Fachlabor können parallel verschiedene Fragen beantwortet werden:
• Liegt eine Schimmelpilzbelastung …


3. Hamburger Fachtagung - Schimmelpilze in Innenräumen jetzt als Hör-CD
Interdisziplinären Tagung zu gesundheitlichen Auswirkungen von Schimmelpilzbefall in voller Länge zum Anhören
Wer die 3. Hamburger Fachtagung „Schimmelpilze in Innenräumen“ verpasst hat, kann sich jetzt nahezu das gesamte Vortragsprogramm ganz bequem zu Hause oder unterwegs anhören. Der Regionalverband Umweltberatung Nord e.V. bietet einen Mitschnitt …


Vortrag: "Schimmelpilze im Innenraum - Das Märchen vom richtigen Heizen und Lüften"
… Lemiesz wird am Montag, 21.02.2011 in der Zeit von 19.30 - 21.00h in der Volkshochschule Neuss, WBZ Raum 15, Hafenstr. 29, 41460 Neuss ein Vortrag über "Schimmelpilze im Innenraum - Das Märchen vom richtigen Heizen und Lüften" halten.
Wo liegt die Wahrheit dass Schimmelpilze in Innenräumen auftreten können ?
Hypothese und Realität klaffen oft auseinander, …


Aus der Praxis – für die Praxis: Fachtagung Schimmelpilze in Innenräumen
… Analyse und Sanierung von Schimmelpilzbefall zu finden. Zum sechsten Mal lud der Regionalverband Umweltberatung Nord (R.U.N.) zur interdisziplinär ausgerichteten Fachtagung „Schimmelpilze in Innenräumen“ ein. Zahlreiche Verbände und Behörden sowie das Umweltbundesamt waren als Kooperationspartner beteiligt. Wieder einmal bot die Tagung den Teilnehmern …


3. Hamburger Fachtagung - Schimmelpilze in Innenräumen
… Schimmelpilzbefall
Bereits zum dritten Mal lädt der Regionalverband Umweltberatung Nord (R.U.N.) am 30. September 2008 zu einer interdisziplinär ausgerichteten Fachtagung zum Thema „Schimmelpilze in Innenräumen“ in die Universität Hamburg ein. Die Tagung steht unter der Schirmherrschaft von Umwelt- und Stadtentwicklungssenatorin Anja Hajduk und wird …
Sie lesen gerade: Schimmelpilze - wie viele Arten sind relevant in Innenräumen